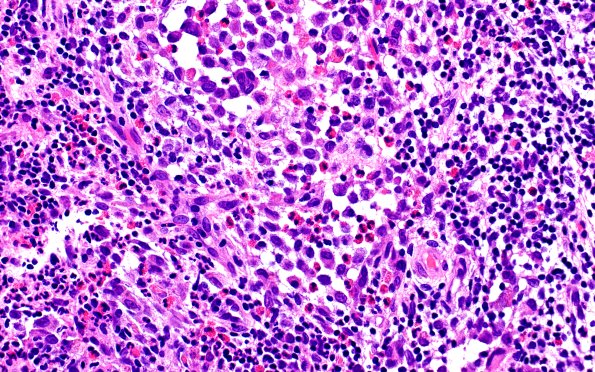
24B7 LCH (Case 24) H&E 40X 5

Table of Contents
Washington University Experience | NEOPLASMS (HEMATOLYMPHOID) | Langerhans Cell Histiocytosis (LCH) | 24B7 LCH (Case 24) H&E 40X 5
The infiltrate includes scattered lymphoid aggregates, numerous eosinophils forming clusters and microabscesses, and aggregates of histiocytic cells with prominent nuclear grooves and nucleoli in a subset. (H&E)